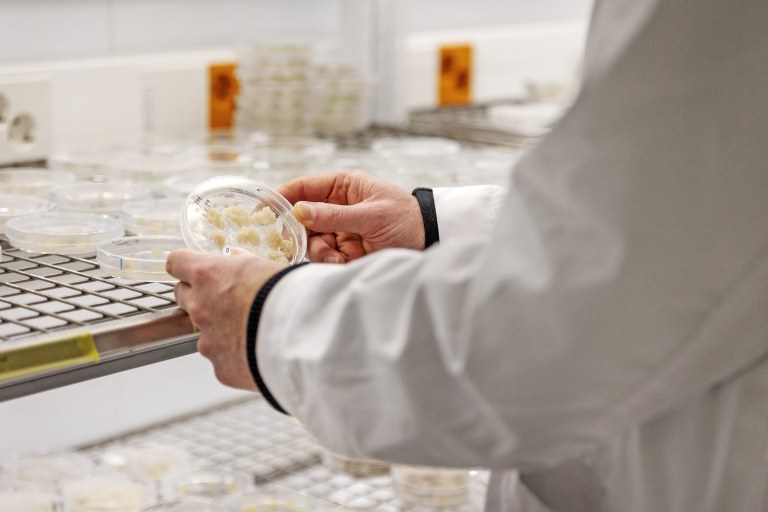
Heiko Rischerin kädet lähikuvassa pitelemässä petrimaljaa.

VTT:ssä on kasvatettu omaa soluviljeltyä kahvisatoa alkuvuodesta 2021. Ensimmäiset omat kahvit juotiin saman vuoden kesällä.
Viime syksynä kahvi laitettiin makutestiin, jossa sitä verrattiin kaupassa myytävään kahviin. VTT:n kahvi oli testaajien mukaan vähemmän paahteista, ja mukana oli savun ja poltetun sokerin makua.
– Meidän solukahvimme ja perinteisen kahvin välillä on selviä samankaltaisuuksia, mutta on myös eroja, VTT:n tiimipäällikkö Heiko Rischer sanoo.
Ilmaston muutos uhkaa kahviakin
Soluviljellylle kahville saattaa olla tulevaisuudessa kysyntää. Kahvinkulutus on maailmalla jatkuvassa kasvussa. International Coffee Organization -järjestön tilastojen mukaan vuonna 2017 maailmassa kulutettiin reilut 165 miljoonaa 60 kilon kahvisäkkiä, kun vuonna 2022 kulutus oli jo yli 178 miljoonaa säkkiä.
Suuri syy kulutuksen lisäykseen on Rischerin mukaan se, että Aasian maat ovat siirtymässä teen juonnista kahvin juontiin.
Kysynnän lisääntymisen lisäksi ilmasto-olot muuttuvat kahvin viljelylle epäsuotuisiksi. Viime vuonna PLOS Climate -tiedelehdessä julkaistiin tutkimus, jossa todettiin, että viimeisen neljän vuosikymmenen aikana kahvisatoa heikentävät ilmasto-olot ovat tulleet entistä säännöllisemmiksi.
Kohoavat lämpötilat tulevat todennäköisesti aiheuttamaan jatkuvan systeemisen shokin maailman kahvin tuotannolle, tutkimuksessa todetaan.
Rischer on kuullut, että kaakaokaupassa tämän vuoden tilanne on ollut huonompi kuin koskaan aikaisemmin. Kaakaota ei ole tarjolla tyydyttämään kysyntää ja hinnat ovat menossa pilviin. Kahvin tilanne on samanlainen.
– Voisi olettaa, että kahvisatojen tilanne kiristyy jatkossa ja hintapisteet vaihtavat paikkaa. Jos haluamme kilpailla jonkin kanssa, meidän on saatava hinta lähemmäksi.
Kasvatus alkaa palasta lehteä
VTT:n kahvi ei ole vielä mitenkään optimoitu tuote, Rischer kertoo. Sitä paahdetaankin vain laboratorion keittiön tavallisessa sähköuunissa.
– Paahtamisella on iso vaikutus, eikä vielä oikein ole olemassa teknologiaa, jolla paahdetaan soluviljelystä saatavaa kahvijauhetta.
(Juttu jatkuu kuvien jälkeen.)

VTT:n solukahvin kasvattaminen alkaa omasta kasvihuoneesta. Kasvihuoneessa kasvatetusta kahvikasvista otetaan pala lehteä, joka ensin steriloidaan.
– Mikä tahansa osa kahvikasvista käy yhtä hyvin soluviljelmän aloittamiseen, Rischer kertoo.
Jokaisen kasvinosan solun perimässä on kaikki se sama informaatio, jolla uuden solukon voi kasvattaa.
– Lehdenpala laitetaan steriilille alustalle oikeanlaisen ravintoliuoksen kanssa. Ravintoliuoksen resepti on salaisuus, siihen pitää löytää oikea yhdistelmä kasvunsäätelijöitä. Tai ei meidän reseptimme enää salaisuus ole, kun julkaisimme sen jo, mutta se pitää kehittää kokeellisesti itse, Rischer sanoo.
Petrimaljassa kasvatetut solut laitetaan seuraavaksi ravintoliuoksen kanssa lasiseen kasvatuspulloon. Pulloa pidetään jatkuvassa liikkeessä. Solut ovat eläviä ja kaasujen pitää päästä vaihtumaan. Kun soluainesta on tarpeeksi, se siirretään bioreaktoriin.
(Juttu jatkuu kuvan jälkeen.)

Lopulta on sadonkorjuun aika. Puuromainen soluaines nostetaan bioreaktorista, ja sen voi kuivattaa jauhoksi ja jauhon paahtaa kahviksi.
Sadonkorjuun kanssa pitää olla tarkkana, Rischer kertoo. Jos solumassaa ei korjaa talteen juuri oikeaan aikaan, ravinteet loppuvat ja solumassa kuolee.
Soluviljely ei vaadi kovinkaan erikoista teknologiaa. Bioreaktorin täytyy olla steriili, ja sen täytyy pitää solumassa oikeassa lämpötilassa, oikeassa pH-arvossa ja jatkuvassa liikkeessä. Solumassan pitää saada sokeria energiaksi, mineraaleja ja kasvun säätelijöitä sekä ilmaa. Samoja aineita, mitä on tarjolla luonnossakin.
Ongelma on skaalaamisessa
Rischer ei osaa arvioida, milloin soluviljeltyä kahvia on kaupoissa. Ongelmana on vielä se, että tuote ei ole saanut kaupallista jalansijaa, ei ole vielä infrastruktuuria, ei liiketoimintaa eikä olemassa olevaa arvoketjua.
– Suurin este on lupaprosessi, ja siihen menee vähintään neljä vuotta, Rischer sanoo.
Ongelma on skaalaamisessa.
– VTT:ssä pystytään kasvattamaan solukahvia tuhannen litran bioreaktorissa, mutta kaupallisessa mielessä se ei riitä mihinkään, Rischer toteaa.
– Tarvitaan paljon isompia installaatioita, mutta teknisesti se ei ole kovin iso ongelma. Se on kustannuskysymys. Tämä on ongelma koko bioteknologian kanssa. Maailmanlaajuisesti on puutetta bioreaktorikapasiteetista, koska useat prosessit ovat menossa tähän suuntaan.
Kilpailu solukahvialalla on kiihtymässä. Maailmalle on tullut kaupallisia yrityksiä, jotka kehittävät soluviljeltyä kahvia, Rischer kertoo. VTT:kin hakee kaupallisia partnereita yhteistyöhön. Se on tutkimusorganisaatio, eikä kaupallistaminen ole sen tehtävä.
Suomen avoimuus toi Heiko Rischerin VTT:lle
Heiko Rischer ei innostunut suomalaisten kahvikulttuurista, kun hän tuli Suomeen VTT:lle töihin vastaväitelleenä tohtorina 22 vuotta sitten.
– Suomalainen kahvi oli silloin vaaleapaahtoista ja kovin hapokasta. Pidän paahteisemmasta, italialaistyylisestä kahvista.
Rischer päätyi Suomeen vastattuaan työpaikkailmoitukseen. Suomea hän piti hyvänä maana tehdä työtä ja asua kahdesta syystä. Ensinnäkin Suomi on EU:n jäsen, ja työpaikan saattoi vapaasti valita EU:n alueelta. Toinen syy on Suomen avoimuus.
– Voin asua täällä ja kulkea ympäriinsä puhumatta suomea, ja se on iso plussa. Muuten en olisi saattanut tulla, se on varmaa. Tutkimusryhmästäni suurin osa on suomalaisia, mutta työkieli on englanti.
Rischerin maahantulon jälkeen suomalainen kahvikulttuuri on monipuolistunut, ja Rischerkin on viihtynyt maassa oikein hyvin. Se on hieman epävarmaa, että minkälainen Suomi tästä eteenpäin on työnperässä maahan muuttaville.
– Nyt oletetaan, että Suomessa tulee olemaan puutetta korkeakoulutetuista asiantuntijoista. Se on koko ajan esillä uutisissakin.
Nykyhallitus on kiristämässä ulkomaalaisten työehtoja Suomessa. Näyttää siltä, että työperusteisen oleskeluluvan ehtoja kiristetään niin, että työsuhteen päättymisen jälkeen erityisosaajilla olisi kuusi kuukautta aikaa hakea uusi työpaikka. Korkeakoulutettujen asiantuntijoiden kohdalla työsopimusten salassapitoehdot ovat usein pitempiä kuin vuoden, Rischer toteaa.
– Jos minulle kävisi niin, että joutuisin hakemaan uutta työtä, niin joutuisin hakemaan ympäri maailman. Muuten en ehkä voisi saada samanlaista työtä.
Sitä Rischer ei osaa arvella, että miten Suomen käy. Kilpailu osaavasta työvoimasta on kova, ja paljon riippuu sitä, mitä muissa maissa tehdään.